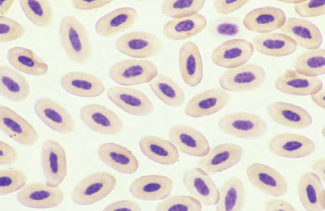
image

CONTENTS
PREFACE
ACKNOWLEDGEMENTS
1 Hematology of Birds
Blood Collection and Sample Preparation
Avian Erythrocytes
Avian Leukocytes
Avian Thrombocytes
Avian Blood Parasites
Avian Hematopoiesis
Hematopoietic Tissue Other Than Bone Marrow
2 Hematology of Reptiles
Blood Sample Collection and Handling
Reptilian Erythrocytes
Reptilian Leukocytes
Thrombocytes and Hemostasis
Blood Parasites
Hematopoiesis
3 Hematology of Amphibians
Blood Collection and Handling
Amphibian Erythrocytes
Amphibian Leukocytes
Amphibian Thrombocytes
Blood Parasites
Hematopoiesis
4 Hematology of Fish
Blood Sample Collection and Handling
Fish Erythrocytes
Fish Leukocytes
Laboratory Evaluation
Thrombocytes and Hemostasis
Blood Parasites
Hematopoiesis
5 Hematology of Small Mammals
Blood Sample Collection and Sample Preparation
Blood Sample Preparation
Erythrocytes
Leukocytes
Platelets
Mammalian Hematopoiesis
Bone Marrow Collection and Evaluation
6 Comparative Cytology
Sampling Techniques
Sample Preparation
Evaluation of the Cytological Sample
Cytological Tissue Groups
Basic Cytological Responses
Body Cavity Fluids
Cytology of the Alimentary Tract: Oral Cavity, Esophagus, Ingluvies, Gastrointestinal, and Cloaca
Cytology of the Respiratory Tract
Cytology of the Skin and Subcutis
Cytology of the Conjunctiva and Cornea
Cytology of Synovial Fluid
Cytology of Lymphoid Tissue and Internal Organs
Cytologic Artifacts
7 Diagnostic Microscopy Using Wet-Mount Preparations
Sampling Techniques
Interpretation of Wet-Mount Preparations
A Stains and Solutions Used in Hematology and Cytology
B Hematologic Values
REFERENCES
INDEX

Terry W. Campbell, DVM, PhD, is an associate professor of zoo medicine at the College of Veterinary Medicine and Biomedical Sciences at Colorado State University.
Christine Ellis, DVM, is formerly of the Midwest Avian and Exotic Animal Hospital and currently works for the Center for Disease Control in Fort Collins, Colorado.
©2007 Terry W. Campbell and Christine K. Ellis
All rights reserved
Blackwell Publishing Professional
2121 State Avenue, Ames, Iowa 50014, USA
Orders: 1-800-862-6657
Office: 1-515-292-0140
Fax: 1-515-292-3348
Web site: www.blackwellprofessional.com
Blackwell Publishing Ltd
9600 Garsington Road, Oxford OX4 2DQ, UK
Tel.: +44 (0)1865 776868
Blackwell Publishing Asia
550 Swanston Street, Carlton, Victoria 3053, Australia
Tel.: +l61 (0)3 8359 1011
Authorization to photocopy items for internal or personal use, or the internal or personal use of specific clients, is granted by Blackwell Publishing, provided that the base fee is paid directly to the Copyright Clearance Center, 222 Rosewood Drive, Danvers, MA 01923. For those organizations that have been granted a photocopy license by CCC, a separate system of payments has been arranged. The fee codes for users of the Transactional Reporting Service are ISBN-13: 978-0-8138-1811-5/2007.
First edition, 1988, Iowa State University Press
Second edition, 1992, Iowa State University Press
Third edition, 2007
Library of Congress Cataloging-in-Publication Data
Campbell, Terry W., 1949-
Avian and exotic animal hematology and cytology / Terry W. Campbell and Christine Ellis.—3rd ed.
p. ; cm.
Includes bibliographical references and index.
ISBN-13: 978-0-8138-1811-5 (alk. paper)
ISBN-10: 0-8138-1811-7 (alk. paper)
1. Birds—Diseases—Diagnosis. 2. Exotic animals—Diseases— Diagnosis. 3. Veterinary hematology. 4. Veterinary cytodiagnosis.
I. Ellis, Christine, DVM. II. Title. [DNLM: 1. Bird Diseases—diagnosis. 2. Cytodiagnosis—veterinary.
3. Hematologic Tests—veterinary. SF 994 C191a 2007]
SF994.C35 2007
636.089'607561—dc22
2006013815
PREFACE
This book provides images and information on the hematology and cytology of avian and exotic animals. It is designed to be used by veterinarians and veterinary technicians in clinical practice, pathologists, laboratory technicians, veterinary students, and those engaged in research involving exotic animals and wildlife. Wildlife researchers may find this information useful in their work in the field. Many of the disorders affecting the hematology and cytology of avian and exotic animal patients can easily be diagnosed in-house without the delay of using an outside commercial laboratory, thus providing the opportunity of treating the patient more quickly with disease-specific therapy. Many pathologists, whose primary training and experience is in diseases of domestic mammals, are not comfortable with the interpretation of blood films or cytologic specimens from exotic animals because they are, in part, unfamiliar with exotic animal diseases and the appearances of their cells. For this reason, brief comments concerning avian and exotic animal diseases have been incorporated in the discussions along with the descriptions of the cellular responses.
The reader will find that for the most part, principles of hematology and cytology, such as sample collection, preparation, and interpretation, of birds and other exotic animals are the same as those for domestic mammals. Knowledge of the hematology and cytology of domestic mammals, especially the dog and cat, will greatly enhance the understanding of the information provided in this book. A basic understanding of the hematology and cytology of domestic mammals will be especially helpful when using the information contained in this book in the clinical setting. A number of books that address the hematology and cytology of dogs and cats are available to assist the reader and have been referenced in this book (Jain, 1993; Cowell et al., 1999; Baker and Lumsden, 2000; Feldman et al., 2000; Raskin and Meyer, 2001; Thrall et al., 2004a).
A few references specifically address the hematology and cytology of the small mammals (also referred to as “pocket pets,” laboratory animals, or exotic mammals) (Hawkey and Dennett, 1989; Jain, 1993; Fudge, 2000; Feldman et al., 2000; Thrall et al., 2004a). Others also specifically address the hematology and cytology of some of the lower vertebrates, such as birds, reptiles, amphibians, and fish (Hawkey and Dennett, 1989; Campbell, 1988, 1995; Jain, 1993; Fudge, 2000; Thrall et al. 2004a). This book is an attempt to create a comprehensive comparative hematology and cytology reference.
The majority of the photomicrographs were taken of Wright’s-stained blood films or cytology slides using 1000× magnification (oil immersion or 100× objective). Other photomicrographs were taken from slides using lower magnifications, such as 400× or 500× , or stained with other stains, such as Diff-Quik, acid-fast, Gram’s, Natt and Herrick’s, phloxine B, Sudan, Macchiavello’s, or Giménez. Wet mount images used in the diagnosis of fish and amphibian diseases were taken from videomicroscopy images using primarily 400× magnifications with the specimens under a glass coverslip.
The hematology chapters are divided into birds, reptiles, amphibians, and small mammals. Each of these chapters follows a similar outline beginning with blood collection and sample handling considerations. The study of the hemogram in each of the hematology chapters is divided into the major groups of cells normally found in peripheral blood, that is, erythrocytes, leukocytes, and thrombocytes or platelets. The discussion of the blood cells is followed by the presentation of the common blood parasites found in the peripheral blood of each respective animal type. Last, each of the hematology chapters ends with a discussion on hematopoiesis.
ACKNOWLEDGEMENTS
I wish to acknowledge all those who have contributed to our knowledge and understanding of veterinary hematology and cytology. I am deeply indebted to those veterinary clinical pathologists whose work and guidance has led me through the understanding of hematology and cytology, which I have used nearly every day in my clinical work. I especially need to acknowledge two pioneers in the study of veterinary hematology and cytology, Oscar W. Schalm, the father of veterinary clinical hematology, and Vic Perman, the father of veterinary clinical cytology. Although they have left us, their work continues on through the efforts of those who have followed their lead. Next, I wish to acknowledge Kerry Keeton and William Moore, who provided my initial instruction and whose tolerance allowed my training to expand beyond that of domestic mammals. I greatly appreciate the writings and lectures provided by Alan Rebar, Dennis DeNicola, Nemi Jain, Joseph Zinkl, Rick Cowell, Ronald Tyler, and Rose Raskin. Their work has greatly influenced my understanding of veterinary hematology and cytology. My friends and current clinical pathology mentors—Mary Anna Thrall, Glade Weiser, Duane Lassen, Linda Vap, Christine Olver, and Paul Avery—deserve special mention and my deepest appreciation. I learn something from each one of them with every encounter. Last, I would like to thank my sons, Brian, Aiden, and Ian, who bring me great joy and happiness each day and who have had to endure a distracted father through numerous weekends and evenings, missing out on many of those important father and son activities. Now that it’s over lads, let’s go to the Islands!
Terry W. Campbell
I would like to thank my parents Charles and Winifred Ellis and my sister Beth for their support through the years as I pursued my dream of becoming a veterinarian—an odyssey I began and that they have patiently endured practically since the day I emerged from the womb. I would also like to thank Jonathan Holden, Distinguished Professor of English and Poet-In-Residence at Kansas State University, for being a touchstone, and for giving me much needed inspiration, encouragement, and direction at a time when I had doubts about the attainability of my dream and of myself as well. I also would like to thank Dr. Terry Campbell because it is through him that I was introduced to the world of exotic animal medicine, and because over the years he has continued to be a source of encouragement and inspiration to me. And finally I would like to thank Dr. Susan Brown and Dr. Richard Nye because without their willingness to mentor me and without their steadfast encouragement and faith in me, I never would have accomplished all that I have in my career.
Christine Ellis
LABORATORY evaluation of avian blood cells consists of a number of tests used to rule in or rule out disease, monitor response to therapy, establish a prognosis, or develop a database. Avian hematology had its beginnings in the early 1960s as a research tool in the poultry industry (Lucas and Jamroz, 1961). In general, the basic hematological principles of domestic mammalian hematology apply to avian hematology with a few differences and modifications. The major differences between mammalian and avian hematology include the presence of nucleated erythrocytes, thrombocytes, and heterophil granulocytes in the peripheral blood of birds. The modified procedures include the use of manual counting techniques to obtain accurate cell counts. These procedures are labor intensive and the reliability of the results depends on the experience and expertise of the individual performing the analysis.
The normal values of any avian hematologic parameter have a broad range owing to the influence of various intrinsic and extrinsic factors. Avian hematological values are subject to extensive variability resulting from different environment and management practices, which can affect physiological responses (Fourie and Hattingh, 1980). For example, heterophil numbers are altered by seasonal changes, diurnal rhythm, gender and age, and diet (Dobinsky and Dobinska, 1976; Maxwell, 1981a; Maxwell et al., 1990; Reddy et al., 1981). Normal hematologic values vary between the avian species as well. The different avian species from which blood samples are submitted to veterinary laboratories create a significant logistical challenge to the development of clinically relevant normal values. Thus, published references should be used only as guidelines.
Blood collection should be performed safely and quickly. Most birds, especially ill birds and small birds such as finches and canaries, are easily stressed when handled. The stress associated with the capture and restraint of the avian patient, especially those that are ill or those not accustomed to being handled, can further compromise the health of the patient and may affect the hematologic indices.
Blood collection for hematologic evaluation in birds begins with proper restraint. Proper restraint of birds has been previously described in other texts and is not discussed in complete detail in this reference (Ritchie et al., 1997; Wilson, 2005). Many birds can be physically restrained without anesthesia for venipuncture. Cloth towels may be used to restrain most of the common pet psittacine and passerine birds. Birds should be held in an upright position or parallel to the floor, and should not be held upside down because this may compromise their respiration. Birds must be able to move the keel (sternum) in order to breathe; therefore, excessive restraint around the body should be avoided to prevent asphyxiation. Last, the wings and legs should be supported during the process of blood collection to prevent injury to those limbs. Many birds become tractable when the head is covered to reduce vision using a snug-fitting lightweight cloth or hood (i.e., cotton sack or pillowcase-type bag). Birds used for falconry or those in raptor rehabilitation facilities often have properly fitting leather hoods available.
Proper restraint of the avian patient should be safe for both the bird and the handler. Some species of birds are capable of inflicting serious injury to the handler. The talons of raptors and the spurs of galliformes can injure handlers so, care should be taken to properly and safely restrain the legs of these birds during venipuncture. The beak of many birds can also serve as a weapon; therefore, proper restraint of the head is required to protect the handlers. Large birds, such as ratites, are especially dangerous as their kicks are potentially lethal to the handlers.
Estimates of the total blood volume in birds range from 6 to 12 ml/100 g (approximately 6%–12% of body weight, and are variable depending upon the species (Sturkie, 1976). For example, the blood volume of the galah (Eolophus roseicapillus) was determined to be 10.6 ± 2.9% of body weight using the indocyanine green method (Jaensch and Raidal, 1998). Using 10% as an estimate of total blood volume, blood samples representing 1% or less of a bird’s body weight can usually be withdrawn from a healthy bird without detrimental effects. For example, a healthy 90-gram cock-atiel (Nymphicus hollandicus) or a 30-gram budgerigar (Melopsittacus undulatus) can easily tolerate the removal of 0.9 ml and 0.3 ml of blood, respectively. The sample size taken from severely ill birds must be reduced to avoid further compromising the health of the patient. For routine hematological evaluations in birds, a sample size of 0.2 ml is usually adequate.
A variety of sites are available for blood collection in birds. The site chosen depends upon the size of the bird, peculiarities of the species, preference of the collector, volume of blood needed, and physical condition of the patient. Blood obtained by venipuncture is used for hematologic studies because venous blood provides the best sample. Capillary blood, such as blood obtained by the clipping of a toenail, is not recommended for hematologic studies. Capillary blood contains abnormal cell distributions, cells, cellular debris, and tissue fluid not found in venous blood, which subsequently interferes with the hematology results. Osteoblasts and osteoclasts in the peripheral blood film have been reported when blood is collected by the toenail clip method owing to the inadvertent biopsy of the third phalanx (Clark and Tvedten, 1999).
A variety of blood collection methods may be used in the avian patient. In general, a short (1.0 inch or less) 25–22-gauge needle attached to a 3 cc syringe may be used when performing venipuncture on the jugular vein or other large veins in most avian species. A needle with an extension tube, such as a butterfly catheter (Abbott Hospitals, Inc., North Chicago, IL), often aids in the stabilization of the needle during sample collection, which may be useful when collecting blood from some species. Once blood is collected into the syringe, it should be quickly introduced into a collection tube after removal of the needle from the syringe. Remove the tube stopper prior to transfer of the sample to prevent hemolysis and clotting. This method allows the blood sample to be divided into various collection tubes or into other containers, depending on the intended use of the sample.
Blood samples are typically collected into syringes containing no anticoagulant. In certain circumstances, use of a syringe containing anticoagulant may be recommended. However, a disadvantage of this technique is that the amount of blood collected is not always predictable and often results in an inappropriate ratio of anticoagulant and blood. Excessive amount of a liquid anticoagulant could cause dilution of the blood sample and abnormal staining of the cells.
Alternatively, blood can be collected following venipuncture by allowing it to flow through the needle and drip into a microcollection device. An advantage of this method is that collecting blood by allowing it to flow through the needle rather than aspirating into a syringe minimizes hematoma formation. A variety of microcollection devices containing ethylenediaminete-traacetic acid (EDTA) are available for hematologic studies (i.e., microtainer tubes, Becton-Dickinson, Rutherford, NJ) and may be utilized for this procedure. Microtainer tubes are also available as plain tubes with or without a serum separator or as tubes containing heparin (lithium heparin is preferred) for blood chemistry studies.
Veins commonly used for venipuncture include the jugular, basilic (cutaneous ulnar, wing or brachial), and medial metatarsal (caudal tibial). Jugular venipuncture can be performed in most species of birds and is the blood collection method of choice for small birds that lack other veins large enough for venipuncture (Law, 1960; Stevens and Ridgeway, 1966; Dein, 1986; Hawkey and Dennett, 1989; Campbell, 1995). Jugular venipuncture allows for a rapid collection time and the ability to easily collect adequate amounts of blood even in small birds, and the tendency for hematoma formation can be minimized with proper attention to technique and hemostasis. The right jugular vein is the site of choice for this procedure because it is typically the larger of the two jugular veins in birds, or may be the only jugular vein present in some species.
The jugular vein tends to be highly movable and is surrounded by a large subcutaneous space that predisposes it to hematoma formation during venipuncture. Therefore, the jugular vein must be stabilized before attempting venipuncture. Following adequate restraint, extend the bird’s head and neck to allow the jugular vein to fall into the jugular furrow along the lateral side of the neck. Lightly wet the feathers with alcohol to expose the featherless tract (apterium) that overlies the jugular furrow. With a few exceptions (pigeons and doves), the jugular vein is visible through the thin skin on the neck. Pressure should be applied to the jugular vein just cranial to the thoracic inlet to occlude and distend the vein, which will facilitate the blood-collection process.
Jugular venipuncture should be performed using an appropriate-sized needle and syringe because the large flow rate and the volume of blood present make it difficult to collect blood as it flows from a needle alone (See Fig. 1.1). Introduce the needle into the vein and collect the blood sample by applying only enough negative pressure on the syringe to allow blood to enter the syringe. More vigorous aspiration will cause collapse of the vein, promotes hematoma formation of the vessel, and may cause hemolysis of the sample. Collection of blood with vacuum tubes is not recommended because of the excessive negative pressure that occurs.
Fig. 1.1. Jugular venipuncture in a bird.

The basilic (cutaneous ulnar, wing, or brachial) vein is a blood collection site that may be utilized in medium to large birds. This method of blood collection will require an assistant to restrain the bird and to apply pressure to the humeral area in order to occlude the vein, because proper restraint is crucial in order to prevent wing movement and hematoma formation. Typically, the bird is restrained in dorsal recumbency. One wing is then stretched away from the bird’s body, with the elbow almost fully extended. Anesthesia may be required to facilitate restraint because many birds will struggle during this procedure.
The basilic vein crosses the ventral surface of the humeral-radioulnar joint (elbow) directly beneath the skin and is easily visualized by wetting the area lightly with alcohol. Using an appropriate-sized needle, blood can be collected following cannulation of this vein either by aspiration into a syringe or by allowing the blood to drip from the needle hub into a microcollection tube (See Fig. 1.2).
To prevent needle movement while aspirating blood into a syringe, the needle can be stabilized by the phlebotomist. This is accomplished by placing the index finger of the free hand alongside the ulna where the basilic vein crosses the elbow. The needle can then be supported as it rests on top of the index finger while it is guided into the vein. If necessary, additional support can be provided by placing the thumb of the free hand on top of the needle. A needle with an extension tube may also minimize needle movement when using a syringe. Hematoma formation is the most common complication associated with this procedure because of movement of the wing or the needle following venipuncture.
Fig. 1.2. Venipuncture of the basilic vein of a bird.

Venipuncture of the medial metatarsal (caudal tibial) vein is another common blood-collection method in medium to large birds. The medial metatarsal vein is located on the caudo-medial aspect of the tibiotarsus just above the tibiotarsus-tarsometatarsal joint, and often hides beneath the calcaneal tendon. In order to access this vein, the bird should be restrained in dorsal or lateral recumbency, with the leg extended. Once the leg is extended and stabilized, a needle is introduced into the medial metatarsal vein at a shallow angle. Blood can be collected by aspiration into a syringe or by allowing blood to drip from the needle hub into a collection tube. Compared to venipuncture of the jugular and basilic veins, hematoma formation is typically minimal following venipuncture at this site because the leg is relatively easy to restrain and the vein is protected by the surrounding muscles of the leg (See Fig. 1.3).
Lancet wounding of vascular structures, such as the basilic vein, medial metatarsal vein, and external thoracic vein, for blood collection should be reserved for very small birds, or when attempts at venipuncture have failed. This method is often used by field researchers collecting small blood samples from small birds. Following alcohol cleansing of the skin overlying the vein, the vessel is punctured through the skin using a lancet (i.e., needle) and the blood is allowed to drip into a microcollection tube.
Fig. 1.3. Venipuncture of the medial metatarsal vein.

Cardiac puncture may be used to collect large volumes of blood (MacArthur, 1944; Andrews, 1950; Utter et al., 1970; Campbell, 1995). This procedure is potentially dangerous and should be reserved for blood sampling from birds used for research or prior to euthanasia.
Cardiac puncture may be performed using an anterior or a lateral approach. Restrain the bird in dorsal recumbency for the anterior approach, and approach the heart by inserting a needle along the ventral floor of the thoracic inlet near the V formed by the furculum. Direct the needle toward the dorsal midline and caudal toward the heart. Care must be taken to avoid the ingluvies (crop) in some avian species. Vibration will be felt in the syringe when the needle is placed properly and the heart is penetrated.
The lateral approach is typically used in galliforme birds and is performed with the bird held in lateral recumbency. Insert the needle at the fourth intercostal space near the sternum (keel), and angle the needle toward the dorsal midline. There may be some species variability with this approach.
The dorsal occipital venous sinus is located at the juncture of the base of the dorsal skull and the first cervical vertebra and may be used to collect large volumes of blood from birds (Vullaume, 1983; Campbell, 1995). Blood collection from the occipital venous sinus requires the use of evacuated glass tubes with appropriate needles and needle holders. Proper restraint is imperative with this technique because of the risk of permanent damage to the brain stem and possible death of the patient. Because of these risks, this method of blood collection should be reserved for birds used in research or prior to euthanasia. Birds should be restrained with the head and neck extended so that the head is positioned in a straight line with the cervical vertebrae. The bird’s head is then firmly flexed ventrally. The dorsal occipital venous sinus can then be located by palpation as a depression between the skull and cervical vertebrae. A needle is inserted through the skin at a 30 to 40 degree angle to the vertebrae. As soon as the needle penetrates the skin, the rubber stopper of the evacuated tube is perforated gently by the needle in the tube holder and the needle is advanced until the sinus is reached (See Fig. 1.4). Penetration of the sinus results in a rapid flow of blood into the tube.
Blood collection using the toenail clip method has been described as a method of sample collection that may be used in avian species, but is a subject of much debate. When this procedure is performed, blood is collected from a toenail that has been clipped to the bleeding quick after it has been cleaned with alcohol and allowed to dry. Blood is collected into a microcollection tube or microhematocrit tube as it drips from the cut nail. Bleeding is then stopped by applying a hemostatic agent (e.g., silver nitrate or ferrous subsulfate) directly to the nail. Proponents of this method feel that it is quick and easy to perform, and causes minimal stress to the bird. Opponents of this method feel that cutting the nail to the bleeding quick is more painful than venipuncture and often birds are temporarily lame following the procedure. The primary disadvantage of this method is that the sample collected from the bleeding nail quick is capillary blood, not venous blood, and often contains cellular debris and cells, such as macrophages, that are not normally found in peripheral blood (Campbell, 1994). For example, osteoblasts and osteoclasts in the peripheral blood film have been reported when blood is collected by the toenail clip method owing to the inadvertent biopsy of the third phalanx (Clark and Tvedten, 1999). Use of the toenail clip method for blood collection in birds should be reserved for very small birds, when other methods for blood collection are not feasible (Murray, 1997).
Fig. 1.4. Blood collection from the occipital venous sinus in a bird (a) using an evacuated tube with needle and holder; (b) by filling an evacuated tube after penetration of the needle into the sinus.

Blood samples collected without the use of an anticoagulant require immediate processing for cell counting following collection. If immediate processing is not possible, blood should be transferred immediately from the syringe into tubes containing an anticoagulant. Most avian blood samples are collected into tubes containing an anticoagulant, such as ethylenediaminetetraacetic acid (EDTA), heparin, or sodium citrate. Regardless of the type of anticoagulant used, hematologic testing should be performed as soon as possible after blood collection to avoid artifacts such as increased cell smudging created by prolonged exposure to any anticoagulant (See Fig. 1.5). Anticoagulant volume should be limited to the smallest amount needed to prevent clot formation. Excessive volume of liquid anticoagulants will dilute the blood sample, resulting in artifactually decreased hematocrit and total cell concentrations. Excess amounts of dry anticoagulants may cause shrinkage of red blood cells, which will affect the hematocrit.
EDTA is the most commonly used anticoagulant. In optimal concentrations, EDTA allows for proper staining of the cells and does not tend to cause clumping of the leukocytes, making it the anticoagulant of choice for hematologic studies (Dein, 1986; Hawkey and Dennett, 1989; Campbell, 1995). However, blood from certain avian groups (crows, jays, ravens, magpies, and some species of ducks, cranes, and hornbills) may show incomplete anticoagulation or partial hemolysis when collected in EDTA, rendering the blood sample unfit for hematologic studies (Dein, 1986; Hawkey and Dennett, 1989; Walberg, 2001; Cray and Zaias, 2004) (See Fig. 1.6).
Fig. 1.5. Clumping and vacuolation of cells and cells with py-knotic nuclei associated with prolonged exposure (48 hours) to EDTA. (Wright’s stain, 1000×)

Heparin prepared at a dilution of 0.2 ml of 1% heparin to 5 ml of blood can substitute for EDTA in situations where the latter cannot be used. Heparin has the advantage of providing anticoagulated blood for hematology, and plasma for blood chemistry evaluations. However, heparinized blood may result in improper staining of cells resulting in erroneous leukocyte counts and poor cellular morphology in stained blood films (Jain, 1986; Dein, 1986; Hawkey and Dennett, 1989; Campbell, 1995). Heparin may also cause clumping of leukocytes and thrombocytes and resultant inaccurate cell counts (See Fig. 1.7). A 3.8% sodium citrate solution used in a ratio of one part citrate solution to nine parts blood is the anticoagulant of choice for coagulation studies.
Fig. 1.6. Blood collected from a magpie (Pica pica) that has undergone hemolysis when exposed to EDTA (tube on the left), but not in heparin (tube on the right).

Fig. 1.7. Clumping of leukocytes and thrombocytes in an avian blood film following exposure of the blood to heparin. (Wright’s stain, 1000×)

A stained blood film is an essential part of the hematologic examination because it provides the opportunity to determine the differential leukocyte count and allows assessment of pathologic abnormalities of the various blood cells. A properly made blood film should contain areas with a cellular monolayer that contains evenly distributed individually dispersed cells. Blood films are made using blood with or without an anticoagulant and using a variety of techniques. Avian blood cells are easily ruptured with improper blood film preparation techniques; therefore, it is advisable to use precleaned, bevel-edged microscope slides to minimize cell damage during blood film preparation. The standard or push-slide method commonly used for preparing human and mammalian blood films can be used to create blood films for avian hematology (Schalm et al., 1975; Coles, 1986; Campbell, 1995; Cray and Zaias, 2004; Lassen and Weiser, 2004). This method involves placement of a drop of blood near one end of a microscope slide that is supported by a solid surface, such as a countertop. The second (pusher or spreader) slide is placed on top of the first slide to form a “wedge” at a 30 to 45 degree angle in front of the drop of blood. The pusher slide is backed into the drop of blood and quickly advanced forward in one rapid motion to create the blood film (See Figs. 1.8a,b). This method usually provides good cellular distribution and adequate monolayer fields for proper slide evaluation; however, cells are commonly damaged when too much pressure is applied to the pusher slide. To minimize cell damage, a drop of commercially available purified bovine albumin can be applied to a glass microscope slide, followed by an equal amount of blood placed on top of the albumin prior to making the blood film. The albumin should not be allowed to dry before making the blood film.
Another method of blood film preparation using the two-slide wedge technique may aid in minimizing cell damage. Hold the slides rather than allowing one of the slides to rest on a firm surface. The slide intended to contain the blood film is held in one hand while the pusher slide is held in the other hand. A drop of blood is placed near the end of the slide farthest from the person making the blood film and the pusher slide is immediately placed in front of the drop of blood. The pusher slide is then quickly backed completely through the drop of blood while being held at an angle of approximately 30 to 45 degrees to the blood film slide. The direction of the pusher slide is immediately reversed toward the opposite end of the blood film slide to make the blood film. The pusher slide, therefore, is brought toward the person making the blood film rather than being pushed away. Most people have better control of the spreader slide when it is being pushed toward them as opposed to being pushed away. This step should be performed in one rapid motion that involves a flip of the wrist holding the pusher slide. The advantage of holding the slides rather than allowing the blood film slide to rest on a solid surface is that less downward pressure can be applied to the pusher slide when making the blood film, which creates less cell damage (See Fig. 1.9).
Fig. 1.8 (a,b) Blood film preparation using the push-slide technique with the slide held on a solid surface and the pusher slide pushed away from the preparer.

Alternately, blood films can be prepared by using a slide and coverslip, or two coverslips. With proper attention to technique, these methods minimize cellular disruption, and maintain good cellular distribution with monolayered areas for examination (Davidson and Henry, 1974; Dein, 1984; Cray and Zaias, 2004). These methods utilize a coverslip that is pulled across a drop of blood that has been placed on a glass microscope slide or another coverslip. Primary disadvantages of this method include the inability to use an automatic stainer, and the potential for cell rupture (smudge cell formation) and improper cell distribution when improper technique is used.
Fig. 1.9 (a,b) Blood film preparation using the push-slide technique with the slide held in one hand and the pusher slide pushed toward the preparer.

Blood-cell stains that have been used for staining air-dried avian blood films for hematological examination include Wright, Wright-Giemsa, Wright-Leishman, and May Grünwald-Giemsa staining methods. Wright stain or Wright-Giemsa modified stains are the most common stains used in the microscopic evaluation of cells in avian blood films. Quick stains or modified Wright stains (i.e., Diff-Quik, Dade Diagnostics, Aguada, Puerto Rico, or Hemacolor, Miles Laboratories, Inc., Elkhart, IN) can also be used to stain avian blood films. These stains are convenient and are the most commonly used stains in veterinary practice settings. The use of automatic slide stainers (i.e., Hema-Tek, Ames Division of Miles Laboratories, Inc., Elkhart, IN, or Harleco Midas II, EM Diagnostic Systems, Inc., Gibbstown, NJ) simplifies the staining procedure and provides a means for consistency and high-quality staining of blood films. Automatic stainers remove much of the staining variation that occurs with the hand-staining methods.
Mature avian erythrocytes are generally larger than mammalian erythrocytes, but are smaller than reptilian and amphibian erythrocytes. Avian erythrocyte size is variable depending upon the species, and generally ranges between 10.7 × 6.1μm to 15.8 × 10.2μm (Sturkie and Griminger, 1986). The mature avian erythrocyte appears as a flattened, elliptical cell with an elliptical, centrally positioned nucleus, and is less deformable and has a higher concentration of free cytoplasmic hemoglobin than mammalian erythrocytes (Smith et al., 2000). The nuclear chromatin is uniformly clumped and becomes increasingly condensed as the cell ages. Typically, the nucleus stains purple while the cytoplasm appears orange-pink with a uniform texture on Wright-stained blood films (See Fig. 1.10).
The total erythrocyte concentration, hemoglobin concentration, and packed cell volume of birds is influenced by age, sex, hormones, hypoxia, environmental factors, and disease (Herbert et al., 1989; Howlett et al., 2002). In general, the total erythrocyte count and packed cell volume (PCV) increase with age and are higher in males than females, because androgens and thyroxin stimulate erythropoiesis, while estrogen depresses erythropoiesis (Herbert et al., 1989). Birds respond to blood loss and blood destruction by increasing erythropoietin production, which stimulates erythropoiesis, much like mammals do. Avian erythropoietin, a glycoprotein produced by the kidney, acts directly on the bone marrow to increase the rate of erythrocyte production. Avian erythropoietin will not stimulate mammalian erythropoiesis and vice versa (Herbert et al., 1989).
Avian hemoglobin is similar to mammalian hemoglobin in that it has four iron-containing heme subunits; however, the protein moieties (globulins) are different (Herbert et al., 1989). Additionally, in avian erythrocytes, the phosphate compounds that influence the affinity of hemoglobin for oxygen are different from those of many mammals. Avian hemoglobin contains myoinositol pentophosphate (IP5), whereas the hemoglobin of many mammals contains 2, 3 diphosglycerate (DPG) (Coates, 1975). Myoinositol pentophosphate causes hemoglobin to have a lower affinity for oxygen and shifts the oxygen dissociation curve to the right of the mammalian curve.
Fig. 1.10. Normal avian erythrocytes. (Wright’s stain, 1000×)
Evaluation of avian erythrocyte morphology involves observation of the cells in a monolayer using a 1000× field of magnification. Approximately half of the erythrocytes should be touching one another (Weiss, 1984). In general, such fields represent approximately two hundred erythrocytes in most species of birds. Monolayer fields may be difficult to achieve in severely anemic birds (i.e., films are too thin) or poorly prepared blood films (films are too thick or too thin). Avian erythrocytes should be evaluated on cellular size, shape, color, nuclear size, shape, and color, and the presence or absence of cellular inclusions. A semiquantitative scale can then be used to estimate the number of abnormal erythrocytes based upon the average number per monolayer 1000× field (See Table 1.1) (Bessis, 1977; Rebar et al., 1981; Weiss, 1984).
The in-house veterinary laboratory evaluation of avian erythrocytes involves the same routine procedures used in mammalian hematology with a few modifications. These basic hematologic procedures include a packed cell volume (PCV) or hematocrit by centrifugation, a plasma total protein estimation by refractometry, determination of hemoglobin concentration by spectrophotometry, erythrocyte concentration by Unopette (Becton-Dickinson, Rutherford, NJ) dilution and use of a hemacytometer, and a stained blood film evaluation.
Table 1.1. Semiquantitative microscopic evaluation of avian erythrocyte morphology.

The PCV provides the percentage of whole blood that is composed of erythrocytes and is determined using the standard manual technique that employs microhema-tocrit tubes, tube sealant, a microhematocrit centrifuge, and a tube-reading card or device. The three distinct layers observed in the spun microhematocrit tube of mammals are also present in avian blood samples. The plasma column is located at the top of the tube, and the packed erythrocytes are located on the bottom. The buffy coat appears as a small, white band located just above the erythrocyte column, and consists of leukocytes and thrombocytes. The buffy coat typically increases in size when the leukocyte concentration increases.
The appearance, color, and clarity of the plasma column above the packed erythrocytes should be noted. Normal avian plasma is typically colorless; however, in some avian species (granivorous birds), it may appear to have a yellow color owing to the presence of diet-related carotene pigments. Icterus is rare in birds because the primary bile pigment of birds is biliverdin (which is green), not bilirubin (which is yellow). Birds lack the biliverdin reductase enzyme needed to reduce biliverdin to bilirubin. Under rare circumstances, icterus can occur in some avian species. In these cases, the source of the bilirubin is likely associated with posthepatic reduction of biliverdin to bilirubin.
Green plasma is suggestive of biliverdinemia (excess biliverdin bile pigment in blood), and typically is indicative of a poor prognosis for survival. Biliverdinemia may be an indication of hepatic failure or renal failure because the avian kidney is normally very efficient at clearing bile pigments from the blood. Currently, there are no commercial biochemical tests available to confirm the presence of biliverdin. Lipemia may be noted in some samples and is most commonly associated with postprandial conditions in birds. It often is not possible to obtain a true fasting blood sample from many avian patients owing to their digestive physiology associated with the presence of a crop (ingluvies). In some cases, lipemic samples may reflect disorders involving lipid metabolism. Hemolysis may occur and usually results from lysis of erythrocytes during blood collection or sample handling. Intravascular hemolysis may also cause hemolysis of the sample in some instances. If the PCV is normal, then the presence of the hemolysis is probably associated with artifactual lysis of erythrocytes.
Plasma protein concentration is typically determined using hand-held refractometers, which have been the standard instruments for determining protein concentration in plasma and body cavity fluid samples since the 1960s (George, 2001). Some authors report good correlation between protein estimation by refractometry and biuret protein in avian samples, but others have not (Morgan et al., 1975; Green et al., 1982; Lumeij and deBruijne, 1985; Andreasen et al., 1989; Lumeij and Maclean, 1996). The major discrepancies between the biuret and refractometric results in these reports may be due to differences in the brand of refractometers used in the study, changes in the alteration of the chemical composition of the biuret reagent, use of different standards, or changes in reaction conditions (George, 2001). Sample-related causes of error in protein determination by refractometric methods include increased nonprotein solids, such as cholesterol, urea, lipoproteins, and glucose (George, 2001). These compounds can increase the refractometric protein measurements by 0.5 to 1.0 g/dl (5–10 g/L) (George, 2001).
Total hemoglobin concentration is typically determined using the standard cyanmethemoglobin method with one modification: the cyanmethemoglobin reagent-blood mixture should be centrifuged prior to analysis. The free nuclei from lysed erythrocytes are removed before obtaining the optical density value, in order to avoid an overestimation of the hemoglobin concentration.
The total erythrocyte concentration in birds can be determined using the same automated or manual methods used for the determination of total erythrocyte counts in mammalian blood. Electronic impedance cell counters provide a rapid, reliable method for obtaining total red blood cell concentrations. Erythrocyte counts with electronic cell counters are slightly inflated by the inclusion of leukocytes and thrombocytes in the count; however, these additional cells are not significant in most samples as they make up approximately 0.1% of the peripheral blood cell population.
Two manual methods for obtaining total red blood cell counts in birds are the erythrocyte Unopette (Unopette, Becton-Dickinson, Rutherford, NJ) method used in mammalian hematology, and the Natt and Herrick’s method, which involves the preparation of Natt and Herrick’s solution to be used as a stain and diluent (Natt and Herrick, 1952) (See Appendix A). A 1:200 dilution of the blood is made using the Natt and Herrick’s solution and red blood cell diluting pipettes.
The use of the erythrocyte Unopette provides an easy method for obtaining accurate dilutions for the total erythrocyte determination because dilutions are made using a provided capillary tube and not a diluting pipette. After mixing, the diluted blood is discharged into a hemacytometer counting chamber and the cells are allowed to settle to the ruled surface for five minutes before counting. The erythrocytes located in the four corners and the central squares of the hemacytometer chamber are counted when using either of the manual methods (See Figs. 1.11, 1.12). The number obtained is multiplied by 10,000 to calculate the total red blood cell count per cubic millimeter (cumm) of blood. Manual counting methods may have an inherent error of 10%; however, they are commonly used because these methods are easily performed in clinical practice.
After the primary hematologic indices (PCV, erythrocyte count, and hemoglobin concentration) have been determined, the secondary hematologic indices can be determined. These include the mean cell volume (MCV) or mean erythrocyte volume (MEV), mean cell hemoglobin (MCH) or mean erythrocyte hemoglobin (MEH), and mean cell hemoglobin concentration (MCHC) or mean erythrocyte hemoglobin concentration (MECH). Published references are available for the erythrocyte indices; however, assessment of abnormal values has not been properly evaluated in birds.
Fig. 1.11. The appearance of erythrocytes in a hemacytometer using the Unopette system. 100 ×)

Fig. 1.12. The appearance of erythrocytes in a hemacytometer using the Natt and Herrick’s solution method. The granular appearing cell is a leukocyte. (Natt and Herrick’s solution, 100×)

The secondary indices are made by calculation using the same formulas (Eqs. 1.1, 1.2, 1.3) used in mammalian hematology and are used for the evaluation of anemia.
1.1 
1.2 
1.3 
In most species of birds, erythrocyte shape is relatively uniform; however, the shape of the red blood cells may be somewhat variable. The degree of poikilocytosis can be estimated using the scale outlined in Table 1.1. Changes that typically occur in the size of avian erythrocytes include microcytosis, macrocytosis, and anisocytosis. These changes should be noted in the assessment of the blood film. A significant change in the mean size of the erythrocyte will be reflected in the MCV. The degree of variation in erythrocytes size (anisocytosis) can be scored 1+ to 4+ based upon the number of variable-sized erythrocytes present in a monolayer field (Table 1.1) (Weiss, 1984). Erythrocyte subpopulations of large cells (i.e., MCV = 308 fl/cell), which most likely represent cells recently released from the hematopoietic tissue. Smaller cells (i.e., MCV = 128 fl/cell), which are older aging cells, have been reported in ducks (Herbert et al., 1989).
Variations in erythrocyte color include polychromasia and hypochromasia. Polychromatophilic erythrocytes occur in low numbers (usually less than 5% of the total erythrocyte count) in the peripheral blood of most normal birds. Polychromatophilic erythrocytes are similar in size to mature erythrocytes and appear as reticulocytes when stained with vital stains, such as new methylene blue. The cytoplasm appears weakly basophilic, and the nucleus is less condensed than the nucleus of mature erythrocytes (See Fig. 1.13). The degree of polychromasia can be graded according to the guideline in Table 1.1.
Hypochromatic erythrocytes are abnormally pale in color when compared to normal mature erythrocytes and have an area of cytoplasmic pallor that is greater than one-half the cytoplasmic volume (See Fig. 1.14). They may also contain cytoplasmic vacuoles and round pyknotic nuclei. A significant hypochromasia will be reflected as a decrease in the MCHC. The degree of hypochromasia can be estimated using the scale in Table 1.1.
Fig. 1.13. The polychromatic avian erythrocytes (arrows) are represented by a light blue cytoplasm. (Wright’s stain, 1000×)

Reticulocytes are the penultimate cell in the erythrocyte maturation series and their presence in the peripheral blood of normal birds suggests that final stages of red cell maturation occur in circulating blood. Determination of reticulocyte concentration can be made by staining erythrocytes with a vital stain, such as new methylene blue. Reticulocytes have a distinct ring of aggregated reticular material that encircles the nucleus (See Fig. 1.15). As the cells mature, the amount of aggregated reticular material decreases and becomes more dispersed throughout the cytoplasm. With further maturation, the reticular material becomes nonaggregated and the cells begin to resemble the “punctate” reticulocytes of felids. Most mature avian erythrocytes contain a varying amount of aggregate or punctate reticulum. Reticulocytes that reflect a current erythrocyte regenerative response are those that have a distinct ring of aggregated reticulum that encircles the red cell nucleus (Campbell, 1995; Hawkey and Dennett, 1989). Significantly high numbers of these cells would represent a regenerative response to anemia.
Fig. 1.14